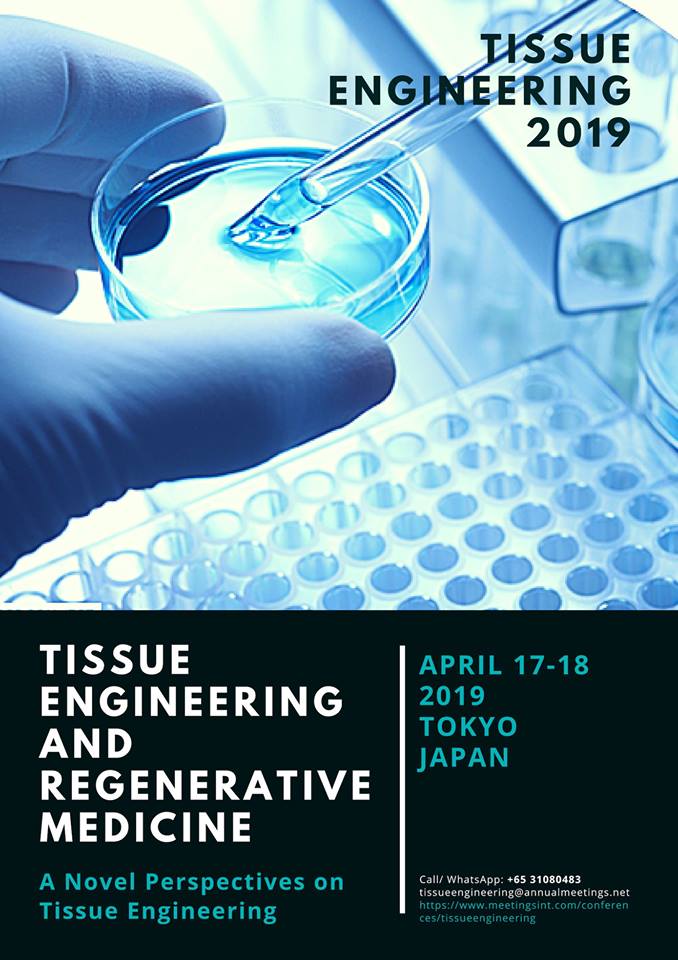
TEngineeering's tweet image. Tissue Engineering 2019 Conference welcomes all the #Tissue_Engineers, #Bio_Medical_Engineers, #Researchers #Students, academic &amp;amp; business delegates Date: 17-18 April, 2019 at Tokyo, Japan. 
For more details contact: meetingsint.com/conferences/ti…

Tissue Engineeering
@TEngineeering
คุณอาจชื่นชอบ
Tissue Engineering 2019 Conference welcomes all the #Tissue_Engineers, #Bio_Medical_Engineers, #Researchers #Students, academic & business delegates Date: 17-18 April, 2019 at Tokyo, Japan. For more details contact: meetingsint.com/conferences/ti…
Present your #researchwork of #Tissue_Engineering, #regenerative_medicine, #Biomaterials #Cell_signaling_technology on International_ Conference of Tissue_Engineering _&_ Regenerative _Medicine April 17-18, 2019 Tokyo, Japan For more details visit: meetingsint.com/conferences/ti…

#Tissue_Engineering_2019 #Regenerative_Medicine #Skin_Tissue_Engineering #Stem_Cell_Research For more details, visit: meetingsint.com/conferences/ti… Meet world’s Renowned Speaker on their exclusive session on "#Skin_Tissue_Engineering” #Tissue_Engineering_2019 17-18 April, 2019 Tokyo

#tissueengineering2019 #Bone_Tissue_Engineering 17-18 April, 2019 at Tokyo, Japan Submit your abstract before early bird date. more detail please visit: meetingsint.com/conferences/ti…

#Tissue_Engineering_2019 #Stem_Cell_Engineering Connect and explore your innovative idea and research at Annual Next-Gen Tissue Engineering and Regenerative Medicine Conference in this April 17-18, 2019 at Tokyo, Japan For more details contact: meetingsint.com/conferences/ti…

#Tissue_Engineering_2019 Honorable Speaker Dr. Chen-Ying Su She is going to give a Keynote Presentation on: Bone and Cartilage Tissue Engineering Tissue Engineering 2019 welcome to all the participants join the conference on 17-18, April, 2019 at Tokyo, japan

#tissue_engineering_2019 #regenerative_medicine Call for Abstract choose the session of your interest. Submit your abstract and register before 30 December, 2018 to avail early bird discount. For more details visit: meetingsint.com/conferences/ti…

United States เทรนด์
- 1. Custom N/A
- 2. #ODEAI N/A
- 3. The ARC N/A
- 4. Good Wednesday N/A
- 5. Corey N/A
- 6. Anton N/A
- 7. Ford N/A
- 8. #alert N/A
- 9. #wednesdaymotivation N/A
- 10. Hump Day N/A
- 11. #signal N/A
- 12. Rickey N/A
- 13. #ConnorStorrieOnTodayShow N/A
- 14. Washington Post N/A
- 15. BLACKPINK N/A
- 16. Defund NED N/A
- 17. Happy Hump N/A
- 18. Boosie N/A
- 19. Rolling Loud N/A
- 20. Griff N/A
Something went wrong.
Something went wrong.














































































